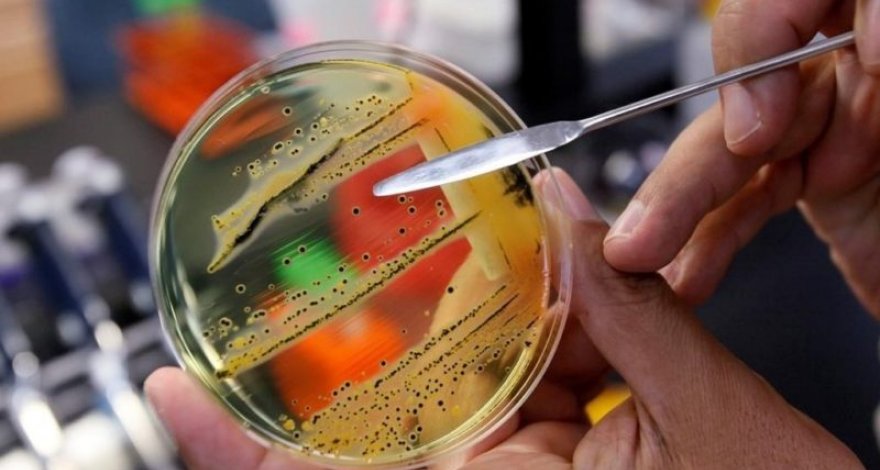
Опасную бактерию сальмонеллу нашли в необычном продукте питания

Специалисты из Управления по контролю за продуктами и лекарствами США (FDA) выпустили заявление, в котором говорится, что опасная бактерия сальмонелла, вызывающая токсикоинфекцию сальмонеллез, обнаружена в популярном собачьем корме, передает «Ридус».
Производитель собачьего корма «Sunshine Mills» подтвердил, что в некоторых образцах премиум корма была обнаружена бактерия. Сальмонеллу нашли во влажном корме с примесью натурального мяса.
После обнаружения сальмонеллы в одном из образцов, специалисты FDA совместно с производителями протестировали другие образцы корма из той же партии, чтобы выяснить процент зараженных продуктов. Как поясняют эксперты, сальмонелла может быть неравномерно распределена по всей партии, поэтому единственное верное решение — отзыв всей партии.
Напомним, что сальмонеллы (Salmonella) — это род бактерий, являющийся возбудителями брюшного тифа, паратифов и других сальмонеллезов. Большинство случаев заражения сальмонеллами происходит с употреблением пищевых продуктов животного происхождения.
Как правило, чаще всего к людям и животным сальмонелла попадает через употребление зараженного сырого мяса, яиц и молока.
Для домашних животных сальмонеллез также опасен, и может привести к летальному исходу. Зараженное животное в последствии может передать инфекцию человеку при тесном контакте.
«Самые явные симптомы сальмонеллеза у животного — это вялость, слабость, диарея, рвота и даже кровавый понос. Если вы знаете, что недавно ваша собака съела что-то из домашней пищи или вы перешли на новый корм, после которого начались такие симптомы, срочно обратитесь к ветеринару», — пишут специалисты FDA.
У людей сальмонеллез обычно приводит к спазмам желудка, лихорадке и диарее. Как правило, большинству заболевших не требуется никакого лечения за исключением большого количества жидкости и постельного режима.
7News.Az